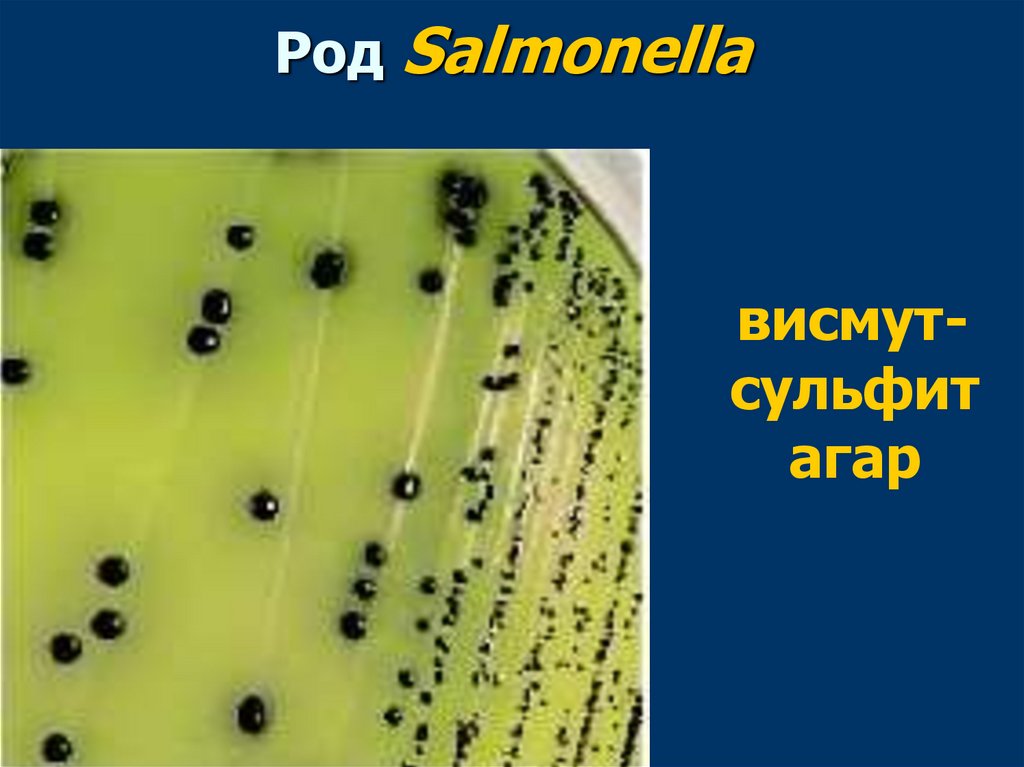
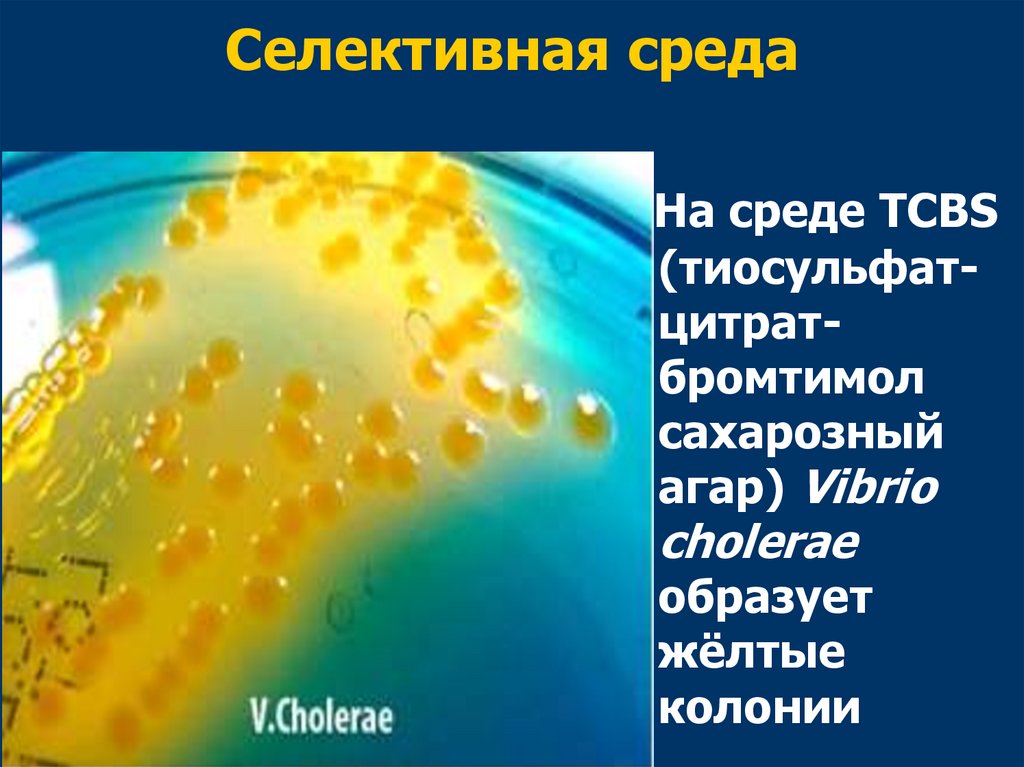

Похожие презентации:
Сальмонеллы и сальмонеллёзы. Возбудитель холеры
1. Сальмонеллы и сальмонеллёзы. Возбудитель холеры.
УРАЛЬСКИЙ ГОСУДАРСТВЕННЫЙ МЕДИЦИНСКИЙ УНИВЕРСИТЕТКАФЕДРА МИКРОБИОЛОГИИ, ВИРУСОЛОГИИ И ИММУНОЛОГИИ
Сальмонеллы и сальмонеллёзы.
Возбудитель холеры.
2.
Сальмонеллы3.
Были открыты в1885 году
американским
ветеринарным
врачом
Д. Сальмоном
4.
Сальмонеллы - это обширнаягруппа бактерий, сходных по
морфологическим,
тинкториальным и культуральным
свойствам, но различающихся по
биохимическим и антигенным
характеристикам
5. семейство Enterobacteriaceae
Согласно современной классификации, основаннойна строении ДНК, род Salmonella состоит из двух
видов - вида S. enterica и вида S. bongori.
В состав вида S. enterica включены все сальмонеллы,
являющиеся возбудителями заболеваний человека и
теплокровных животных.
6. В зависимости от источника инфицирования выделяют:
брюшной тиф и паратифы (возбудители:Salmonella typhi, S. paratyphi A, S.
paratyphi В)
сальмонеллезы (возбудители:
сальмонеллы животного происхождения,
бипатогенные –
S. typhimurium и т.д.)
7. Род Salmonella
8. Род Salmonella
9.
Тинкториальные свойства(окраска по Граму)
10.
Возбудителибрюшного тифа и паратифов
11.
Salmonella enterica subsp. enterica serovarTyphi
Salmonella enterica subsp. enterica serovar
Paratyphi A;
Salmonella enterica subsp. enterica serovar
Paratyphi B
subsp. (сокр. от ла. subspecies) — подвид
12.
Salmonella Typhi,S. Рaratyphi A,
S. Рaratyphi В
13. Культуральные свойства
Факультативные анаэробыПодвижные
Растут на простых питательных
средах – колонии - S формы
Дифференциально-диагностические
среды - Эндо, Левина, Плоскирева –
колонии - лактозоотрицательные
14. Культуральные свойства
Среды обогащения (жидкиеселективные питательные среды для
выделения сальмонелл): среда
Мюллера, селенитовая среда,
магниевая среда, желчная
среда, среда Рапопорт
15. Культуральные свойства
Дифференциально-диагностическиесреды – висмут-сульфит агар
Колонии:
черные (S. Typhi),
темно-зеленые (S. Paratуphi A),
черные с валиком (S. Paratуphi B)
16. Род Salmonella
висмутсульфитагар
17.
висмут-сульфит агарS. Typhi
S. Paratуphi B
18. Среда Клиглера
Лактозаглюкоза
Н2S
S.Typhi
S. Paratуphi А
S. Paratуphi B
19. Антигенное строение
Соматический О-антигенЖгутиковый Н-антиген
Капсульный К-антиген
Vi-антиген (Аг-вирулентности)
20. схема Кауфмана-Уайта (1934)
По О-антигену - 50серологических групп
По Н-антигену - на
серологические варианты:
- специфическая фаза - (a,b…),
- неспецифическая фаза - (1,2…)
21. Антигенная структура Классификация по Кауфману-Уайту
ГруппаНаименование
Соматич
еский
(О) Антиген
Жгутико
вый (H)
антиген
Фаза 1
Жгутико
вый (H)
антиген
Фаза 2
О2
A
S.paratyphi A
1,2,12
a
-
О4
B
S. paratyphi B
1,4,5,
12
b
1,2
О7
C1
S.Paratyphi C
6,7,Vi
C
1,5
О9
D
S.typhi
S.enteritidis
S.dublin
S.panama
9,12,Vi
1,9,12
1,9,12
1,9,12
d
g,m
g,p
iv
1,5
Идентифи
кация
абсорбиро
ванной Оантисывор
откой
22. Брюшной тиф
Salmonella TyphiАнтропонозная инфекция
Источник инфекции - человек -
больной или носитель
Механизм передачи инфекции -
фекально-оральный
Путь - водный
23. Клинические проявления
Брюшной тиф - остраяинфекционная болезнь,
проявляющаяся
продолжительной лихорадкой,
высыпаниями на коже,
кишечным расстройством и
тяжелой интоксикацией.
24. Факторы патогенности
Фимбрии и белки наружноймембраны – факторы адгезии;
Эндотоксин (ЛПС);
Антифагоцитарный фактор - Vi
антиген
25. Патогенез брюшного тифа
1.Возбудитель брюшного тифа с пищейили водой попадает в желудок.
Под действием желудочного сока
часть бактерий погибает, а
оставшиеся клетки проникают в
тонкий кишечник.
Для развития заболевания
достаточно 100 тыс. микробных
клеток.
26. Патогенез брюшного тифа
2. Адгезия сальмонелл на клетках кишечникаосуществляется с помощью пилей
(ворсинок).
Проникновение сальмонелл в стенку
кишечника происходит через М-клетки.
Затем сальмонеллы размножаются и
транспортируются в подслизистый слой, где
захватываются макрофагами.
27. Патогенез брюшного тифа
3. Внутри макрофагов сальмонеллыразмножаются и попадают в пейеровы
бляшки, вызывая их воспаление – это
первичный очаг инфекции.
Защиту сальмонелл от фагоцитоза
обеспечивает Vi-АГ.
28. Патогенез брюшного тифа
4. Из пейеровых бляшек сальмонеллы с током лимфыпереносятся в лимфатические узлы, где
размножаются и поступают в кровь, обусловливая
первичную бактериемию.
Это происходит в конце инкубационного периода, т.
е. через 10-14 суток после инфицирования.
В этот период возбудитель обнаруживается в крови
больного.
29. Патогенез брюшного тифа
5. В кровеносном русле частьсальмонелл разрушается. При этом
высвобождается эндотоксин, который
вызывает лихорадку и развитие
тифозного статуса.
При тяжелом течении заболевания
может развиться инфекционнотоксический шок.
30. Патогенез брюшного тифа
6 Сальмонеллы разносятся по организму, оседают в.
печени, селезенке, костном мозге, почках, что
приводит к поступлению в кровь большого
количества сальмонелл (вторичная бактериемия).
Из печени через желчные протоки с током желчи
сальмонеллы возвращаются в кишечник.
В результате этого наступает реинфекция тонкого
кишечника (вторая неделя болезни).
31. Патогенез брюшного тифа
7. Из кишечника часть сальмонеллвыводится с калом, а другая часть
бактерий вновь внедряется в пейеровы
бляшки.
Повторное внедрение сальмонелл в
сенсибилизированные пейеровы
бляшки приводит к развитию в них
воспаления, их некрозу и изъязвлению.
32. Патогенез брюшного тифа
8. На третьей – четвертой неделе встенке кишки формируются глубокие
язвы.
При поражении стенки сосуда
возникает кровотечение.
На пятой-шестой неделе происходит
заживление язв.
33. Исход заболевания
В большинстве случаев бактерииполностью элиминируются из
организма.
Однако в 3-5% случаев формируется
бактерионосительство, при котором
сальмонеллы остаются в костном мозге
или желчном пузыре.
Брюшной тиф может сопровождаться
рецидивами и осложнениями. Наиболее
опасным осложнением является
прободение стенки кишечника и
развитие перитонита.
34. Иммунитет
После перенесенного брюшноготифа развивается напряженный и
длительный (пожизненный)
иммунитет.
Повторные заболевания возникают
редко.
35. Лабораторная диагностика
Первая неделя болезни -гемокультура
Вторая неделя - серодиагностика
(реакция агглютинации Видаля)
Третья неделя - копро- и
уринокультура
36.
ДИАГНОСТИКА БРЮШНОГО ТИФАI неделя
Материал:
кровь - гемокультура
1. Среды накопления (желчный бульон)
2. Среды дифференциально-диагностические
(Левина, Плоскирева, висмут-сульфид агар)
Лактоза «-» колонии
3. Получение чистой культуры - среда Олькеницкого
4. Биохимическая активность – среда Клиглера
5. Реакции агглютинации с антисыворотками О серогруппа D - О -9, Vi, Н - d
37. Антигенная структура Классификация по Кауфману-Уайту
ГруппаНаименование
Соматич
еский
(О) Антиген
Жгутико
вый (H)
антиген
Фаза 1
Жгутико
вый (H)
антиген
Фаза 2
О2
A
S.paratyphi A
1,2,12
a
-
О4
B
S. paratyphi B
1,4,5,
12
b
1,2
О7
C1
S.Paratyphi C
6,7,Vi
C
1,5
О9
D
S.typhi
S.enteritidis
S.dublin
S.panama
9,12,Vi
1,9,12
1,9,12
1,9,12
d
g,m
g,p
iv
1,5
Идентифи
кация
абсорбиро
ванной Оантисывор
откой
38.
ДИАГНОСТИКА БРЮШНОГО ТИФАII неделя
Материал: сыворотка крови - серодиагностика
Реакция агглютинации Видаля
(реакция развернутой агглютинации)
Определение титра антител в сыворотке крови
больного к О- и Н -АГ
39. Реакция агглютинации Видаля (реакция развернутой агглютинации)
40.
ДИАГНОСТИКА БРЮШНОГО ТИФАIII неделя
Материал: фекалии, моча, желчь,
соскоб с розеол
копро- , уринокультура, при
исследовании желчи - биликультура
41. Лабораторная диагностика
При подозрении на брюшнотифозноеносительство исследуют сыворотку
крови на наличие антител к Vi-антигену
с помощью реакции непрямой
гемагглютинации (РНГА) с
эритроцитарным диагностикумом к Viантигену.
42. Специфическая профилактика
Vi-полисахаридная вакцинаВ состав данной вакцины входит
очищенный Vi-АГ, полученный из S.
Typhi.
Вакцина вводится подкожно или
внутримышечно однократно детям с 2летнего возраста и взрослым.
43.
Сальмонеллы животногопроисхождения
(бипатогенные сальмонеллы)
44.
Сальмонеллы животногопроисхождения
(бипатогенные сальмонеллы)
S. typhimurium, S. choleraesuis и
т.д.
45. Сальмонеллы животного происхождения
Первичным источником являются животные:крупный рогатый скот, свиньи,
водоплавающие птицы, куры, грызуны
Заражение связано с употреблением:
мяса - до 70 – 75%,
птицепродуктов – до 10%,
молочных продуктов – около 10%,
рыбы – около 3 – 5% случаев
Человек (больной, особенно стертой формой
сальмонеллеза, или бактерионоситель).
46. Сальмонеллы животного происхождения
Механизм передачи –фекально-оральный
Пути –
алиментарный,
водный,
контактно-бытовой.
47. Факторы патогенности
У бипатогенных сальмонелл имеются:факторы адгезии и колонизации,
факторы инвазии,
эндотоксин,
экзотоксины:
термолабильные и термостабильные
энтеротоксины типа LT и ST;
шигаподобные цитотоксины.
48.
49. Клинические формы
гастроинтестинальнаягипертоксическая
остролихорадочная
тифоподобная
септическая
субклиническая форма
носительство
50. профилактика
Специфическая профилактика неприменяется.
Неспецифическая профилактика:
ветеринарно-санитарные мероприятия–
предупреждение сальмонеллезов среди
животных и птиц;
санитарно-гигиенические – защиты
пищевых продуктов от заражения;
противоэпидемические – выявление
носителей, больных, их лечение.
51. Возбудители холеры
52.
Холера — острая инфекционнаяболезнь, характеризующаяся
поражением желудочно-кишечного
тракта, нарушением водносолевого обмена и обезвоживанием
организма.
Относится к карантинным
инфекциям.
53.
Возбудители холеры относятся к:семейству Vibrionaceae
роду Vibrio
вид Vibrio cholerae
Выделяют 2 биологических варианта:
V. сholerae биовар asiaticae
(возбудитель классической холеры)
V. cholerae биовар eltor (возбудитель
холеры Эль - Тор)
серовар О139 (Бенгал) (возбудитель
холеры в Юго - Восточной Азии)
54.
В распространении холеры выделяют 4 периода:1-й период (от древнейших времен до 1817 г.) -
холера эндемичное заболевание для стран,
расположенных в бассейне рек Ганга и
Брахмапутры.
2-й период (1817—1926 гг.) зарегистрировано
шесть пандемий холеры, всякий раз
охватывавших Россию, унесших миллионы
человеческих жизней. Все 6 пандемий были
связаны с Vibrio cholerae.
55.
3-й период (1926—1960 гг.) —формирование стойких эндемичных
очагов холеры в Юго-Восточной Азии.
4-й период (с 1961 г. по настоящее время)
соответствует седьмой пандемии холеры,
которая охватила страны Азии,
Ближнего и Среднего Востока.
Особенность 7-й пандемии холеры появление нового варианта холерного
вибриона -Vibrio cholerae eltor, который
долгое время считали непатогенным.
56.
С 1990 года регистрируются эпидемии, вызванныехолерным вибрионом серогруппы О139 (Бенгал), в
странах Южной и Юго-Восточной Азии.
Были отмечены завозы возбудителя холеры Бенгал
в США, Германию, Англию, Данию, Эстонию,
Россию, Японию, Кыргызстан, Узбекистан,
Казахстан и Китай.
По данным ВОЗ (на 2018 г.) ежегодно в мире
регистрируется 499 447 случаев заболевания
холерой, 2990 случаев смерти от холеры.
57.
Возбудительхолеры V. cholerae
впервые был
выделен в чистой
культуре и изучен
Р. Кохом в 1882 г.
58.
В 1906 г. на карантинной станции ЭльТор (в Египте) супруги Ф. и Е. Готшлихвыделил из трупов паломников вибрион,
отличающийся от вибриона Коха
гемолитическими свойствами.
Как впоследствии оказалось V. cholerae
eltor также вызывает холеру
59. Vibrio cholerae
60. Биологические свойства
Холерные вибрионы имеют формуизогнутой палочки (0,5—3,0 мкм).
Спор и капсул не образуют.
Имеют один полярно
расположенный жгутик.
Хорошо окрашиваются
анилиновыми красителями,
грамотрицательные.
61.
Тинкториальные свойства(окраска по Граму)
62. Культуральные свойства
Факультативные анаэробы (предпочитаютаэробные условия).
Хорошо растут на простых питательных
средах с щелочной реакцией (pH 8,5 - 9,5).
На 1% щелочной пептонной воде образует
нежную пленку (через 6 часов).
На щелочном агаре - гладкие прозрачные
колонии с голубоватым оттенком (14-16
часов).
63. Селективная среда
На среде TCBS(тиосульфатцитратбромтимол
сахарозный
агар) Vibrio
cholerae
образует
жёлтые
колонии
64. Антигенное строение
Н-видоспецифический.По О-АГ выделяют серологические группы –
от О1 до О206.
V. cholerae и V. cholerae eltor — возбудители
холеры — относятся к серогруппе 01.
Антиген 01 состоит из компонентов А, В и С,
разные сочетания которых присущи
серотипам: Огава (АВ), Инаба (АС) и
Гикосима (Хикоджима)(ABC).
65. НАГ-вибрионы
Вибрионы, лишенные 01-антигена,называются неагглютинирующимися (НАГ)
вибрионами.
Они вызывают гастроэнтериты, энтериты.
Vibrio cholerae O139 Bengal (не
агглютинируется 01 сывороткой , но
агглютинируется специфической O139антисывороткой).
66. Холера
Антропонозная инфекцияИсточник инфекции - человек - больной или
вибрионоситель
Заражающая доза составляет около 1 млн.
микробных клеток.
Заражение человека от человека не происходит.
Механизм передачи инфекции - фекально-
оральный
Пути – водный, алиментарный, предметно-бытовой
67. Факторы патогенности
жгутик (обеспечивает подвижность),муциназа (разжижает слизь и облегчает
достижение поверхности эпителия),
нейраминидаза (обеспечивает
взаимодействие с микроворсинками),
эндотоксин.
68. Факторы патогенности
Экзотоксин (холероген).Холероген вызывает в тонкой кишке
активацию аденилатциклазной системы и
как следствие этого — накопление цАМФ,
что приводит к интенсивному выделению из
клеток воды, ионов натрия и хлора и
одновременно — нарушению процесса
поступления ионов калия внутрь клеток.
Клинически этот процесс проявляется
обильной диареей.
69. Клинические проявления
инкубационный период - от нескольких часовдо 5 суток
острое начало
водянистая диарея «рисовый отвар»
рвота
лихорадка
«лицо Гиппократа»
снижение тургора кожи — «руки прачки»
гипотония, тахикардия, нитевидный пульс,
слабость, заторможенность, ступор
70. Клинические проявления
Холерный алгид (лат. algidus холодный)симптомокомплекс, обусловленный
обезвоживанием организма с потерей
хлоридов натрия и калия и
бикарбонатов, характеризующийся
гипотермией, гемодинамическими
расстройствами, анурией, тоническими
судорогами мышц конечностей, резкой
одышкой.
71. Лабораторная диагностика
Холера - опасное заболевание. Поэтомубактериологическое исследование
нужно проводить в режимных
лабораториях, в которых работает
специально подготовленный персонал.
На диагностику отводят – 48 часов.
72. Лабораторная диагностика
Материал - испражнения, рвотные массы,промывные воды желудка больного.
1 этап - из исследуемых материалов
изготовляют мазки, фиксируют смесью
Никифорова, окрашивают по Граму.
Холерные вибрионы выглядят в виде
своеобразных скоплений, которые
напоминают «стайки рыб».
73. Лабораторная диагностика
1 этап Одновременно проводят посевисследуемого материала на жидкие и
на плотные питательные среды ( 1%
щелочную пептонную воду, щелочной
МПА, селективную среду TCBS ).
74. Лабораторная диагностика
2 этап Через 5-6 час инкубации посевов втермостате изготовляют мазок из пленки на
поверхности жидкой среды (висячую каплю)
для определения подвижности и проводят
ориентировочную реакцию агглютинации на
стекле с O1 (или O139) диагностической
сывороткой.
75. Лабораторная диагностика
3 этап Через 16-24 час. выращиванияпосевов на плотных элективных средах
проводят микроскопическое исследование
изолированных колоний и пересев с целью
выделения чистой культуры и ее
идентификации.
76.
Основные отличия между V. сholere и V. сholere еltorТесты
V.
сholere
V. еltor
Гемолиз эритроцитов барана
±
±
Агглютинация куриных эритроцитов
±
±
Рост на агаре с полимиксином (30 од/мл)
-
+
Лизис холерным фагом С
+
-
Лизис фагом еltor
-
+
77. Лабораторная диагностика
4 этап учитывают результат идентификациичистых культур и выдают окончательный ответ о
выделении холерного вибриона серогрупы: О1
(Инаба, Огава, Гикошима) или 0139.
Обязательно отмечают гемолитическую
активность, чувствительность к антибиотикам и
лизис культуры соответствующим бактериофагом.
78. Лабораторная диагностика Фаготипирование
Холерный диагностический фаг Сизбирательно лизирует холерные вибрионы
классического типа.
Фаг Эль-Тор - вибрионы Эль-Тор.
Существуют фаги, лизирующие вибрионы
обоих типов.
Холерные бактериофаги используются в
диагностических целях и практически не
имеют терапевтического значения.
79. Методы ускоренной диагностики
метод иммунофлуоресценции,метод иммобилизации вибрионов под
воздействием специфической холерной
О1 сыворотки,
ПЦР
80. Специфическая профилактика
Вакцина холерная (Холероген-анатоксин и О-антиген) жидкая.
Вакцинации подлежат взрослые и
дети старше 7 лет по
эпид.показаниям.
81.
Компьютерный контрольпо разделу "Частная
бактериология 1"

Медицина
Медицина








